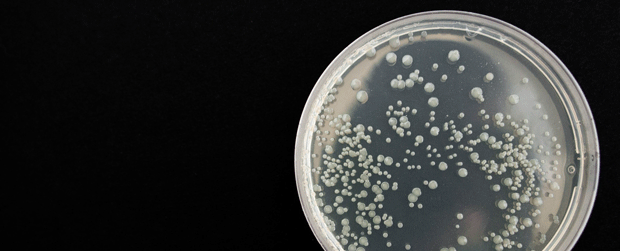

Eine Gruppe von Forschern, zusammengesetzt aus Experten der argentinischen Universitäten Rosario und Conicet, erforschte nun die lebensverlängernde und dem Altersprozess entgegenwirkende Fähigkeit des Bakteriums Bacillus subtilis.
Die aufsehenerregende Studie bewies nicht nur, dass das probiotische Bakterium positive Auswirkungen auf das Immunsystem hat, sondern auch das Leben verlängern kann.
Denn auch wenn die Effekte des Bakteriums bereits bekannt waren, wurden sie erst jetzt an einer Fadenwurmart namens Caenorhabditis elegans genauer untersucht. Diese Organismen dienen in der Entwicklungsbiologie als beliebte Modellorganismen, da sich über sie gewonnene Erkenntnisse auf ein breites Organismenspektrum übertragen lassen - inklusive des Menschen.
Für den Leiter der Untersuchung, Roberto Grau, steht fest, dass das Bakterium nicht nur das Leben der Fadenwürmer verlängert, sondern auch entscheidend zu deren Vitalität beiträgt. Übertragen auf die Menschen würde das bedeuten, dass sie mit deren Hilfe mehr als 120 Jahre alt werden und dabei aber die Lebenskraft eines 50Jährigen haben könnten!
Im Unterschied zu anderen Bakterien müssen diese Probiotika nicht gekühlt werden, um ihre positiven Effekte zu erzielen. Außerdem bilden sie Sporen, die überaus resistent sind. Sie sprießen nach dem Verzehr und bringen so die aktiven probiotischen Bakterien mit all ihren gesundheitsfördernden Wirkungen hervor.
Bild: © CC0 Public Domain, Pixabay.de